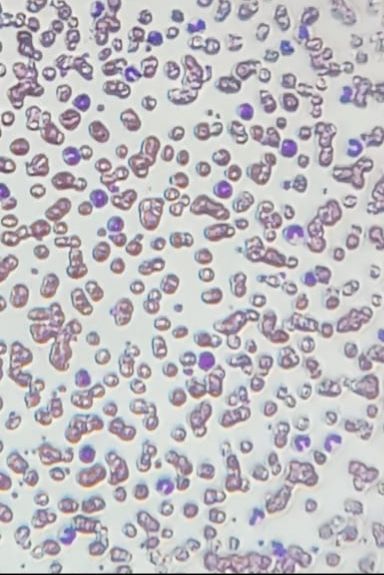

Blood smear showing severe neutrophilia with left shift
 Dec 07, 2018 • 11:12 AM UTC
Dec 07, 2018 • 11:12 AM UTC Unknown Location
Unknown Location 140x Magnification
140x Magnification Unknown
Unknown
Navrose Sangha
Learn about the author...
208posts
0comments
1locations
View in Media Gallery
Sign in to commentNobody has commented yet... Share your thoughts with the author and start the discussion!

 0 Applause
0 Applause 0 Comments
0 Comments

















